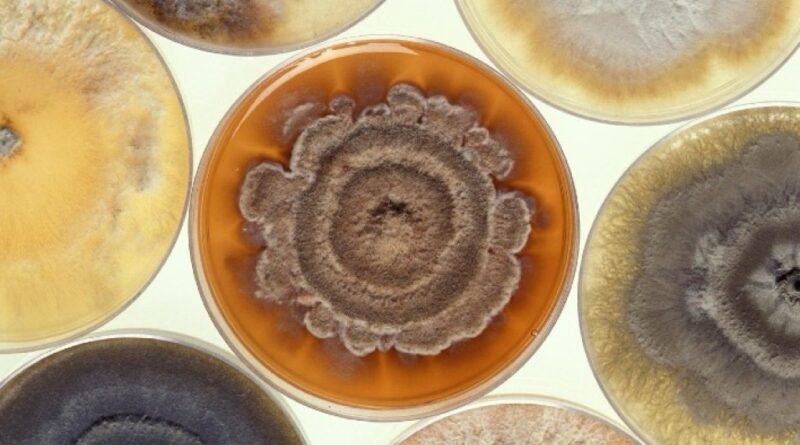

Ballagro e Symbiomics firmam parceria para acelerar desenvolvimento de biodefensivos no Brasil
As empresas Ballagro e Symbiomics, referências no setor de biológicos, anunciaram uma parceria estratégica voltada ao desenvolvimento de soluções biológicas inovadoras para proteção de culturas no Brasil. O acordo prevê a integração dos portfólios de microrganismos das duas companhias, com o objetivo de acelerar a criação de produtos de alto desempenho.
A Ballagro terá acesso à plataforma exclusiva da Symbiomics, que permite um desenvolvimento mais rápido e assertivo, enquanto a Symbiomics agrega sua expertise em tecnologias de ponta, como edição genômica e inteligência artificial (IA).
Mercado global de biológicos em rápida expansão
O setor de produtos biológicos para agricultura apresenta crescimento acelerado. Segundo dados da empresa americana DurhamTrimmer, o mercado global foi estimado em US$ 14 bilhões em 2024, com 60% representados por produtos de controle biológico, e deve alcançar US$ 20 bilhões até 2027, crescendo a uma taxa média anual de 13%.
Essa expansão reflete a integração crescente entre defensivos químicos e bioinsumos, motivada pela busca por soluções mais sustentáveis e eficientes no manejo de pragas e doenças, especialmente em culturas de larga escala, como soja, milho e cana-de-açúcar.
Ballagro: mais de 20 anos de experiência em bioinsumos
Com mais de duas décadas de atuação, a Ballagro desenvolve soluções biológicas e nutricionais sinérgicas e de alta performance, voltadas para diversas culturas. A empresa possui estrutura própria, altos padrões de qualidade e atua de forma sustentável, sendo parceira essencial no Manejo Integrado de Pragas no Brasil.
Segundo Lecio Kaneko, gerente de Desenvolvimento Estratégico da Ballagro, “a parceria com a Symbiomics permitirá explorar novos campos, como o entendimento do DNA dos microrganismos, acelerando a criação de uma nova geração de bioinsumos com alta tecnologia”.
Symbiomics: inovação com IA e biotecnologia
A Symbiomics tem se destacado no desenvolvimento de produtos biológicos de alto desempenho, utilizando ferramentas avançadas como edição genômica e inteligência artificial.
Para Jader Armanhi, COO e cofundador da empresa, “a parceria permite acelerar o desenvolvimento em duas a cinco vezes em relação a métodos tradicionais, unindo inovação tecnológica à experiência industrial da Ballagro, transformando descobertas em soluções disponíveis para o campo”.
Brasil: liderança em bioinsumos na América Latina
A América Latina tem ganhado destaque no setor de bioinsumos, com o Brasil liderando em área tratada e taxa de adoção. O país deve ampliar sua participação no mercado mundial de 20% em 2021 para 29% em 2029, consolidando-se como polo global.
De acordo com a ANPII Bio, o mercado brasileiro movimentou R$ 5,7 bilhões na safra 2023/2024 e deve superar R$ 9 bilhões até 2030, um crescimento de cerca de 60% na década.
Desenvolvimento de novos microrganismos
Atualmente, o Brasil possui mais de 600 registros de biodefensivos à base de microrganismos junto ao MAPA, abrangendo apenas 18 gêneros e 45 espécies, mostrando concentração de mercado em ativos limitados.
Rafael de Souza, CEO e cofundador da Symbiomics, destaca que “nosso objetivo é identificar microrganismos robustos, competitivos frente à microbiota natural, para criar novos produtos com grande potencial de mercado no Brasil e internacionalmente”.
Fonte: Portal do Agronegócio
Fonte: Portal do Agronegócio